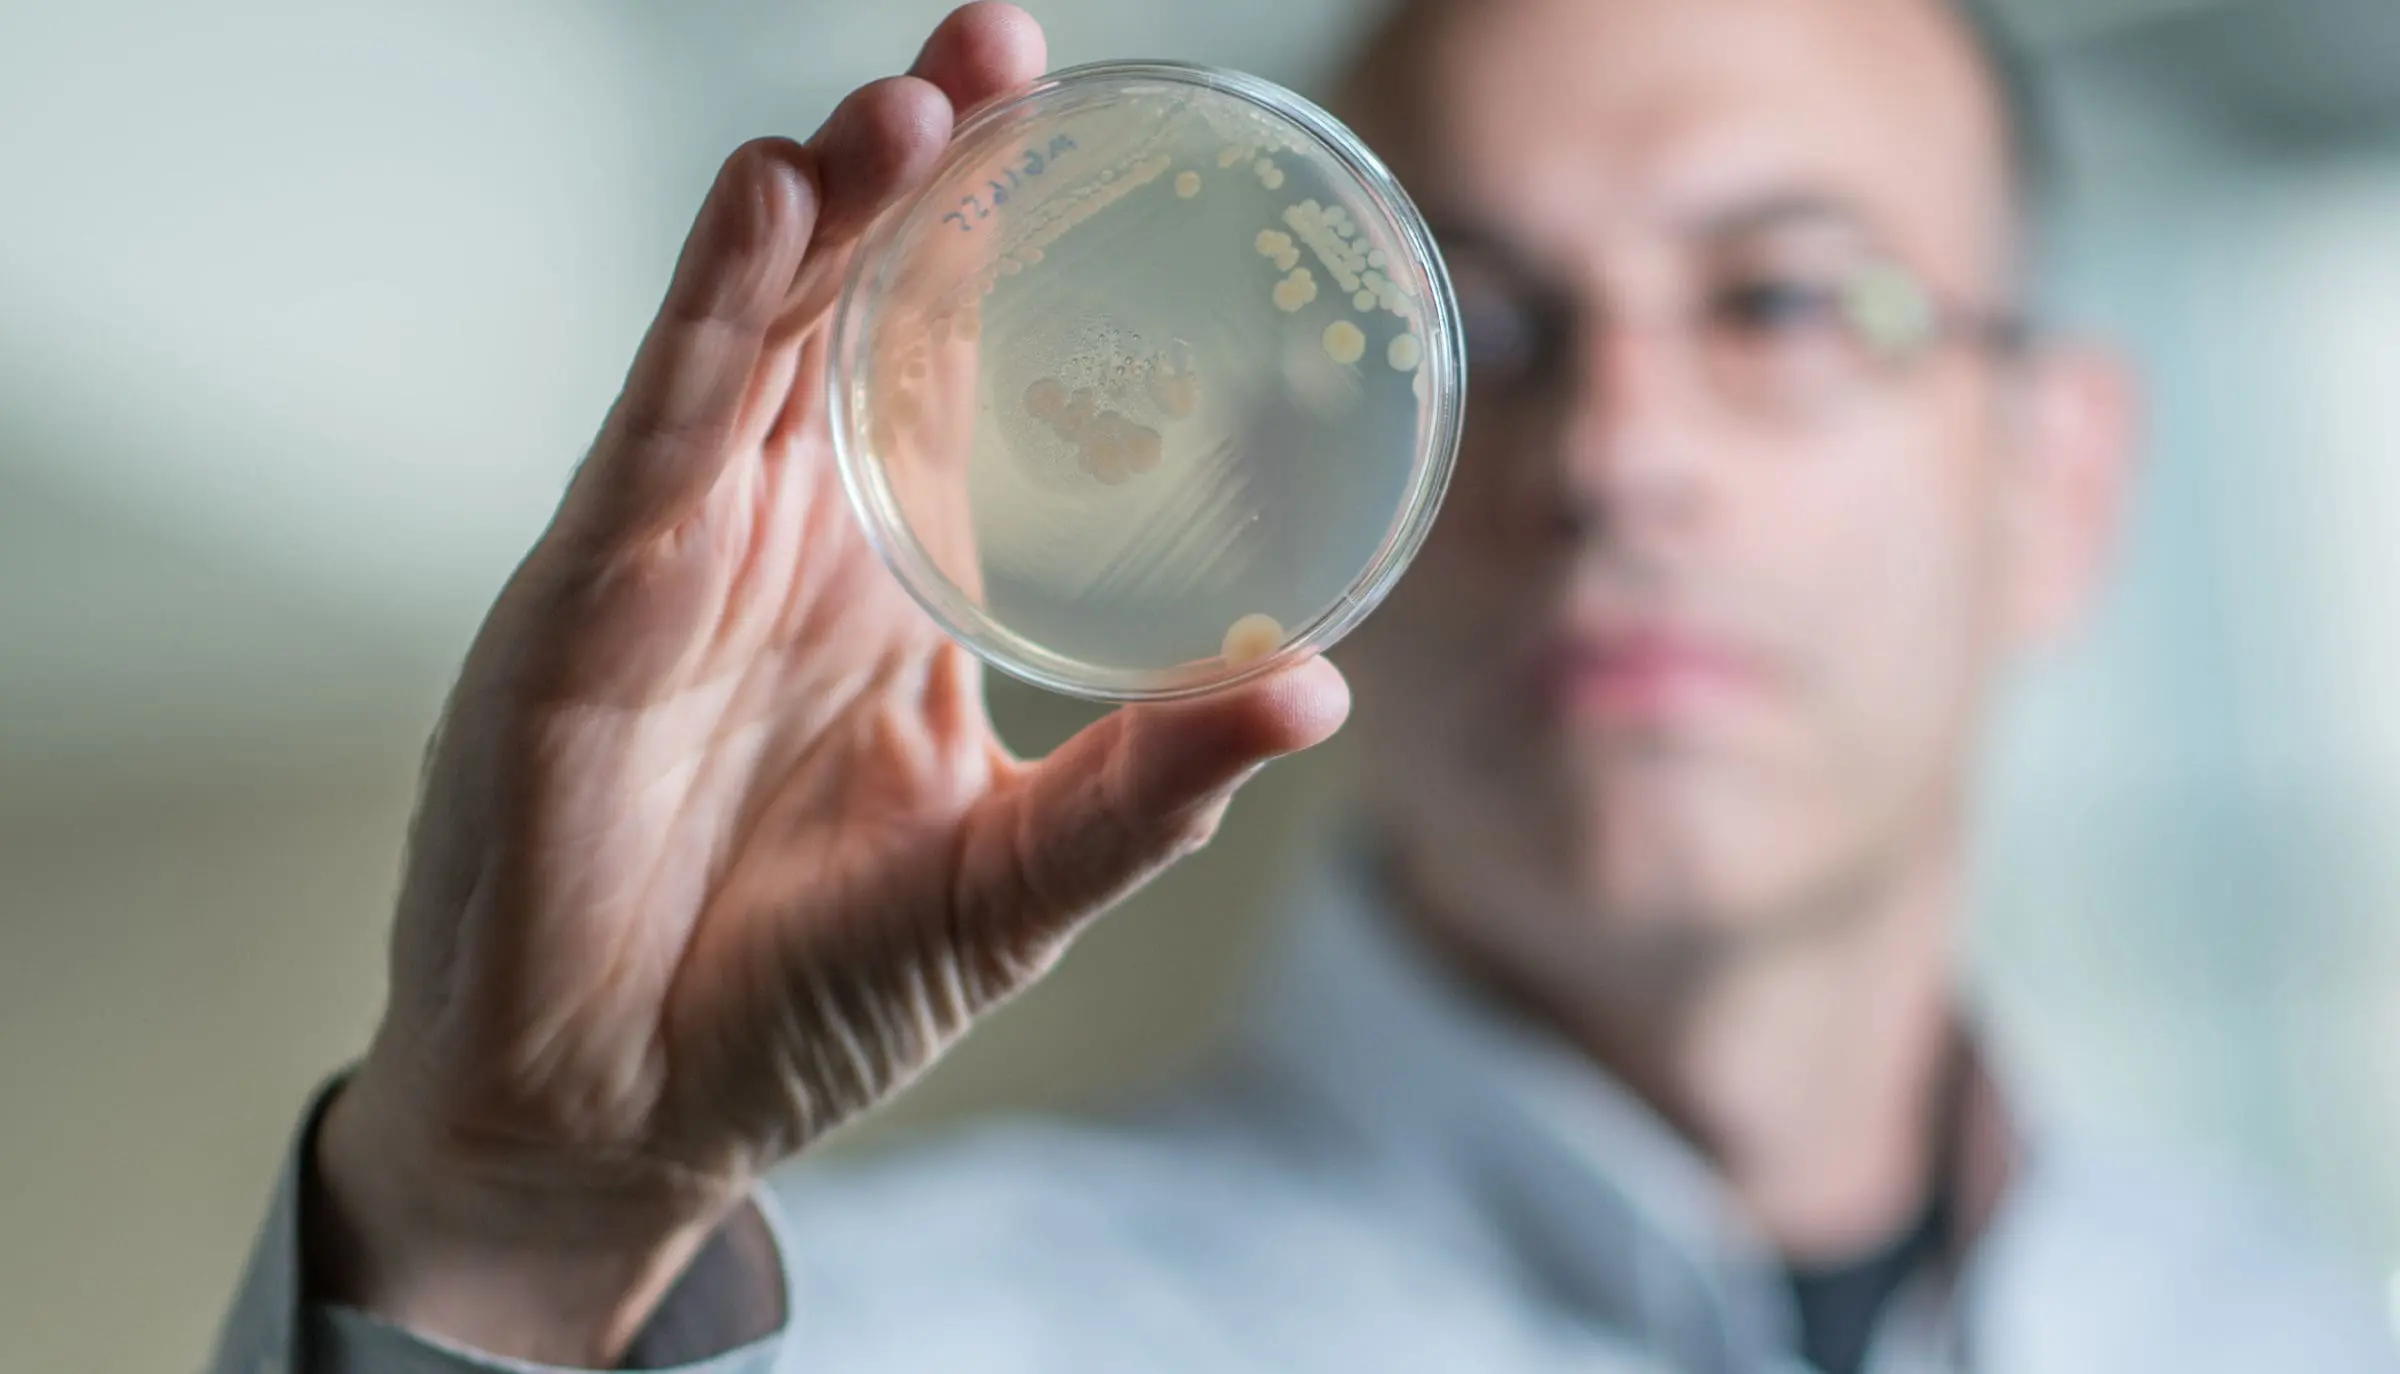

Cornell Tech Hosts First-Ever Summit on Disability, Access, and AI


Visionary Education
Cornell Tech Hosts First-Ever Summit on Disability, Access, and AI
Thetis AI Charts a Smarter, Cleaner Future for Global Shipping


Entrepreneurship
Thetis AI Charts a Smarter, Cleaner Future for Global Shipping
Excel Turns 40: Meet the Israeli Team Behind It


High-Tech Future
Excel Turns 40: Meet the Israeli Team Behind It
Tumor Freezing: A Breakthrough in Cancer Treatment


Health & Medicine
Tumor Freezing: A Breakthrough in Cancer Treatment
Animals Revolutionize Future of Organ Transplants


Health & Medicine
Animals Revolutionize Future of Organ Transplants
Wearable Microneedle Patch Offers Real-time Diabetes Tracking


Health & Medicine
Wearable Microneedle Patch Offers Real-time Diabetes Tracking
The Man Behind the Pentium Chip, Now Behind the Technion’s Future


High-Tech Future
The Man Behind the Pentium Chip, Now Behind the Technion’s Future
Technion Innovations: The Science Powering What’s Next Part 1


Entrepreneurship
Technion Innovations: The Science Powering What’s Next Part 1
Israeli-Developed AI Blood Test Treats Depression


Health & Medicine
Israeli-Developed AI Blood Test Treats Depression
The Unlikely Path to a $497 Million Israeli Exit


Entrepreneurship
The Unlikely Path to a $497 Million Israeli Exit
Runaway Dead Stars Are Clues for a Cosmic Mystery


High-Tech Future